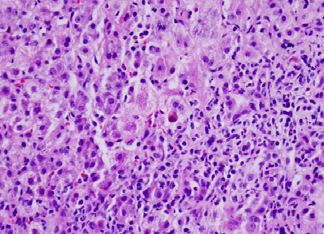

Not Just the Stomach Flu: A Case of Acute Liver Failure after Adenovirus Infection
- 0. These Authors equally contribute to this paper
- 1. Department of Pediatrics, Children’s Hospital Los Angeles, USA
- 2. Department of Pediatrics, Division of Gastroenterology and Nutrition, Children’s Hospital Los Angeles and Keck School of Medicine at University of Southern California, USA
ABSTRACT
Adenovirus is a common viral infection with variable clinical presentations, including respiratory tract infection, conjunctivitis, and gastroenteritis. In immunocompromised patients, it can present more severely with liver failure, renal failure, encephalitis, pancreatitis, myocarditis, and even disseminated disease. We report a case of acute liver failure caused by adenovirus in a previously healthy two-year-old child, whose illness spontaneously resolved. Although adenovirus is a rare cause of fulminant liver failure, it should be considered in the differential diagnosis, even in presumably immunocompetent children.
KEYWORDS
Acute liver failure, Adenovirus
CITATION
Vayngortin T, Pai AK, Thomas DW (2014) Not Just the Stomach Flu: A Case of Acute Liver Failure after Adenovirus Infection. Ann Pediatr Child Health 2(2): 1014.
INTRODUCTION
Acute liver failure (ALF) is a state in which the synthetic and excretory functions of the liver are compromised by hepatocyte destruction. Classical definitions of ALF are challenging to apply to children who may not exhibit typical adult signs of asterixis, tremors, fetor hepaticus, and encephalopathy. Furthermore, etiologies of ALF differ in pediatric and adult populations. The Pediatric Acute Liver Failure Study Group (PALFSG), a consortium of twenty-four domestic and international pediatric hospitals, has consensus criteria for ALF in children: no prior history of chronic liver disease, biochemical evidence of liver injury, INR greater than 1.5 (PT ≥15 seconds) not corrected by Vitamin K in an encephalopathic patient, or INR greater than 2.0 (PT≥20 seconds) for a patient without encephalopathy [1].
According to a 2011 report from the United Network for Organ Sharing (UNOS) Directory, ALF accounted for 10.6% of the 1,668 pediatric liver transplants in the US between 2009- 2011 [2]. For these patients, attempting to identify the etiology and initiating therapy is critical. In a 2006 PALFSG report, ALF was attributed to acute acetaminophen (APAP) toxicity (14%), metabolic disease (10%), autoimmune liver disease (6%), nonAPAP drug-related liver toxicity (5%), infections (6%), and other diagnosed conditions (10%) for the first 348 patients enrolled in the study [1]. Of note, the underlying etiology was considered indeterminate in 49% of the study population. The prevalence of the known etiologies varies by age. In infants (<90 days), neonatal hemochromatosis, viral infections, and metabolic diseases were the most common known etiologies of ALF [3]. In older children (≥3 years old), drug toxicity (APAP and non-APAP), autoimmune disease, and Wilson’s disease were more common [1].
Only 6% of the PALFSG patients were found to have identifiable infections, with herpes simplex virus (HSV) predominating in children <3 years old and Epstein-Barr virus (EBV) being more common in children ≥3 years old [1]. To diagnose a viral etiology of ALF, the PALFSG requires either the presence of a serum IgM antibody, evidence of the virus in liver tissue, or a positive polymerase chain reaction (PCR) [1]. Although hepatitis A, B, and C are uncommonly found in US pediatric populations, in endemic areas, ALF is attributed to these viruses more frequently [4,5]. Other viruses implicated in hepatic failure include adenovirus, enterovirus, herpes simplex virus (HSV), cytomegalovirus (CMV), parvovirus B19, human herpesvirus-6 (HHV-6), and varicella zoster virus (VZV).
The following case highlights important issues for pediatricians. It demonstrates that ALF has variable presentations in children compared to adults. Children are often healthy prior to onset of liver disease and clinicians must be vigilant in recognizing altered mental status, hemodynamic instability, fever, vomiting, pruritis, respiratory distress, weight change, and bruising, because symptoms can progress rapidly with sudden clinical deterioration [6]. When a pediatrician suspects ALF, it is critical to transfer the patient to a liver transplant center immediately. This case also cautions us not to underestimate adenovirus, a common DNA virus that causes respiratory tract infections, gastroenteritis, febrile illnesses, and conjunctivitis. Although it is often dismissed as having a benign clinical course in immunocompetent patients, adenovirus infection has potentially serious sequelae. Through quality improvement initiatives, the PALFSG has emphasized the value of reporting cases such as this one because nearly half of the children who develop ALF carry an idiopathic diagnosis as its cause [7].
CASE PRESENTATION
A previously healthy two-year-old Hispanic boy presented with one week of fussiness, scleral icterus, non-bloody, nonbilious emesis, tactile fevers, increased frequency of bowel movements with acholic stool, decreased appetite, and a six pound weight loss. He did not have pruritis, rash, cough, conjunctivitis, myalgias, or joint pain prior to illness onset. The boy did not have a travel history outside of Los Angeles, sick contacts at home, family history of autoimmune disease, ingestion of medications or herbal supplements, or other known toxin exposures. Initial examination was significant for scleral icterus and hepatomegaly, but the patient had no stigmata of chronic liver disease.
Admission labs were remarkable for AST 3566, ALT 2189, AlkPhos 502, Tbili 7.5,Cbili 3.6, PT 16.1, INR 1.6, and PTT 24. Abdominal ultrasound with Doppler revealed a mildly enlarged, coarsened, echogenic liver with normal vascular flow and a gallbladder with a thickened wall and debris. Empiric treatment with piperacillin/tazobactam, acyclovir, and fluconazole was initiated as his workup proceeded. The patient had an acetaminophen level of <10 mcg/mL and infectious labs included negative blood PCRs for CMV, EBV, HSV, and HHV-6. His hepatitis panel included a non-reactive HepA antibody, HepC antibody, HepE antibody, HepB surface antigen, and a reactive HepB surface antibody. Blood cultures remained negative throughout his illness course. His metabolic and autoimmune workup was also unremarkable, with levels of ceruloplasmin, anti-nuclear antibody (ANA), anti-soluble liver antigen antibody (SLA Ab), anti-liver kidney microsomal antibody (LKM Ab), anti-smooth muscle antibody all within normal limits. The “ZZ” phenotype of alpha-1-antitrypsin (A1AT) was not detected. After undergoing a liver biopsy by Interventional Radiology, he was transferred to the PICU for two days due to increased irritability and confusion, concerning for hepatic encephalopathy.
The liver biopsy (see Figure 1)
Figure 1: The liver parenchyma has necro-inflammatory changes with apoptosis (arrow) and Kupffer cell hyperplasia. Lymphocytes are predominant, but other inflammatory cells such as plasma cells, eosinophils, and neutrophils are also present. There is no evidence of fatty change, Mallory bodies, epithelioid granuloma formation, viral inclusions, stainable iron, or malignancy.
showed acute parenchymal inflammation with necrosis and minimal portal fibrosis. Although immunoperoxidase stains for the viruses did not reveal any definitive inclusions, the patient’s adenovirus blood PCR detected a viral load of 5192 copies/mL. The patient improved without intervention, with AST 92, ALT 151 within one week of discharge and neurologic status returning to baseline. He is now clinically well, one year later.
DISCUSSION
Our patient developed ALF presumed to be secondary to adenovirus, as his work-up was negative except for a positive adenovirus blood PCR and a liver biopsy consistent with viral hepatitis. The classic clinical presentations of adenovirus include fever, conjunctivitis, gastroenteritis, and respiratory tract infection [8]. However, immunocompromised patients often present with more severe manifestations including hepatitis, encephalitis, pneumonitis, hemorrhagic cystitis, nephritis, pancreatitis, myocarditis, and disseminated disease [8]. Our patient presented solely with symptoms of liver disease, including hepatomegaly, scleral icterus, acholic stools, and altered mental status; he met criteria for ALF. Although he was evaluated for liver transplantation, he was not transplanted because his overall course was self-limited and liver function tests eventually normalized.
There are not many reported cases in the literature of immunocompetent children with adenovirus-induced ALF. Hosnut described an 18-month-old boy with a similar clinical presentation to our patient, but with a much higher bilirubin and INR. This patient was treated with plasmapheresis and died from multiple organ failure [9]. In a retrospective study from Texas Children’s Hospital, Munoz. found that out of 440 patients with adenovirus, 11 had disseminated disease (defined as involvement of more than two organs), and 5 of these patients were immunocompetent (although only 3 of 5 were previously healthy). Unlike our patient, all of these patients had respiratory tract symptoms. They found that immunocompetent children were more likely to have respiratory tract involvement, whereas immunocompromised children were more likely to have gastrointestinal involvement. They also established that disseminated disease tended to occur at a younger age in immunocompetent children (average 11 months) than in immunocompromised children (average 22 months) [10]. Another review of 143 patients with adenovirus in Primary Children’s Medical Center in Salt Lake City by Rocholl included only one patient with hepatitis. This patient was immunocompetent and presented with pancreatitis, encephalopathy, fulminant liver failure, and pneumonia. He was successfully treated with Cidofovir [11]. A Taiwanese report by Chuang [12] described nine immunocompetent patients, seven of whom were previously healthy, with severe adenovirus infection. Although six patients had hepatitis, all of them had respiratory tract infections, and several had involvement of other organ systems. Eight of their patients were initially treated with antibiotics, as was our patient, and three patients received Intravenous Immunoglobulin (IVIG); one patient died of disseminated intravascular coagulation.
The “gold standard” for diagnosing adenovirus is viral culture [11]; however, this method is cumbersome. Because the virus has many serious complications, rapid diagnosis is important and can be accomplished by PCR. Other methods of diagnosis include: viral antigen assays, histology, serology, immunohistochemistry, in-situ hybridization, and electron microscopy. In our patient, adenovirus was diagnosed by blood PCR. His liver biopsy demonstrated inflammation, consistent with an infectious etiology such as adenovirus. Immunostaining on our liver biopsy specimen was negative for all viruses. In the case report by Hosnut the patient’s liver biopsy also demonstrated hepatic necrosis, without any inclusion bodies, and negative adenovirus PCR [9]. However, both this patient and ours had a positive blood PCR confirmation of adenovirus, which may be more sensitive and specific.
Adenovirus is usually self-limited, and no anti-viral drugs have been approved for treatment. Several studies have reported successful treatment with Cidofovir [8,13], IVIG [8,12,14] and Ribavirin [8,12]. Although our patient improved without antiviral therapy, this treatment may be indicated for some patients. Lynch et al. recommend considering treatment for disseminated disease (>2 organs), severe pneumonia, high viral load, virulence or trophism of the viral strain, persistent severe lymphopenia, or immune deficits [13].
In the literature, adenovirus ALF has only been reported in the setting of disseminated disease or in immunocompromised patients. To our knowledge, this is the first reported case of a previously healthy child without any typical respiratory tract symptoms of adenovirus presenting solely with liver involvement and having a self-limited illness. We believe that when previously healthy pediatric patients present with ALF, adenovirus should be considered. Adenovirus infections may mimic other serious bacterial infections, so this viral etiology must remain on the differential diagnosis. Any patient presenting with ALF should be transferred to a liver transplant center.
ACKNOWLEDGEMENT
We would like to thank Dr. Larry Wang from the Department Of Pathology for providing the image for the manuscript.
REFERENCES
2. 2011 Annual Report of the U.S. Organ Procurement and Transplantation Network and the Scientific Registry of Transplant Recipients: Liver. Department of Health and Human Services, Health Resources and Services Administration, Healthcare Systems Bureau, Division of Transplantation, Rockville, MD; United Network for Organ Sharing, Richmond, VA.
5. Lee WM, Seremba E. Etiologies of acute liver failure. Curr Opin Crit Care. 2008; 14: 198-201.
6. Cochran JB, Losek JD. Acute liver failure in children. Pediatr Emerg Care. 2007; 23: 129-135.
13. Lynch JP 3rd, Fishbein M, Echavarria M. Adenovirus. Semin Respir Crit Care Med. 2011; 32: 494-511.